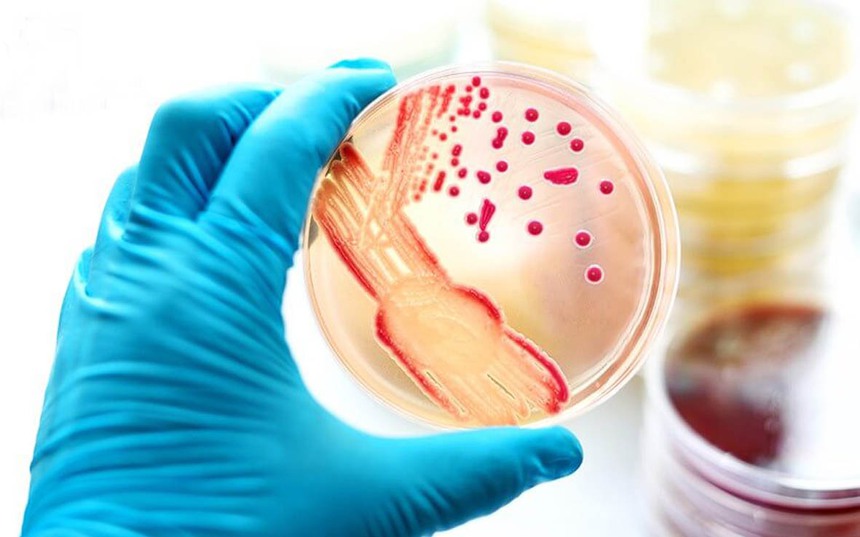
Chuyên gia y tế khuyến cáo các biện pháp phòng ngừa bệnh đậu mùa khỉ - Ảnh 1.

Cơ quan y tế hai tỉnh Đồng Nai, Bình Dương cho biết đã ghi nhận ca mắc đậu mùa khỉ trên địa bàn. Trước mắt chưa xác định được nguồn lây nhiễm của ca bệnh. Như vậy, tính đến nay, cùng với 2 ca được phát hiện năm 2022, Việt Nam đã ghi nhận 4 trường hợp mắc bệnh đậu mùa khỉ. Ở Việt Nam, Bộ Y tế xếp đậu mùa khỉ là bệnh truyền nhiễm nhóm B.
Thạc sỹ, Bác sỹ Lương Chấn Quang, Phó trưởng khoa kiểm soát và Phòng ngừa bệnh tật trực thuộc Viện Pasteur Thành phố Hồ Chí Minh đã chia sẻ một số thông tin liên quan đến diễn biến bệnh đậu mùa khỉ tại khu vực phía Nam; cũng như đưa ra các khuyến cáo để phòng, ngừa bệnh này trong tình hình hiện nay.
Thạc sỹ, Bác sỹ Lương Chấn Quang cho biết: Theo thông tin, cả 2 ca bệnh đậu mùa khỉ hiện nay đều được phát hiện và xét nghiệm vào những ngày cuối tuần. Ngay khi ghi nhận ca bệnh nghi ngờ mắc đậu mùa khỉ đến khám chiều 22/9, Bệnh viện Da Liễu Thành phố Hồ Chí Minh đã điều tra, hội chẩn và lấy mẫu gửi Viện Pasteur Thành phố Hồ Chí Minh, xét nghiệm có kết quả sáng 23/9. Với trường hợp thứ hai, Trung tâm kiểm soát bệnh tật tỉnh Bình Dương xác minh, điều tra và lấy mẫu gửi đến Viện Pasteur Thành phố Hồ Chí Minh vào chiều tối 23/9, kết quả xét nghiệm được trả lời vào sáng 24/9. Việc điều tra xác minh ca bệnh và người tiếp xúc được Trung tâm Kiểm soát Bệnh tật tỉnh, thành phố triển khai sau khi có thông tin ca bệnh nghi ngờ, không đợi đến khi có kết quả xét nghiệm.
Ảnh: Internet
Viện Pasteur Thành phố Hồ Chí Minh với vai trò chỉ đạo, điều phối đã tổng hợp và chia sẻ thông tin giữa các tỉnh, thành phố kịp thời xác định các yếu tố nguy cơ, người tiếp xúc gần ban đầu nhằm đáp ứng nhanh với tình huống bệnh. Các địa phương đang tiếp tục điều tra mở rộng các địa điểm, nhóm người tiếp xúc với hai trường hợp bệnh theo phương châm "gõ từng nhà, rà từng đối tượng" để xác định nguồn lây và phát hiện sớm các trường hợp bệnh khác (nếu có).
Theo bác sỹ Lương Chấn Quang, các thông tin hiện có cho thấy cả hai bệnh nhân khởi bệnh tại nơi cư trú, chưa có yếu tố tiếp xúc người nước ngoài hoặc đi nước ngoài trong thời gian gần đây. Trong bối cảnh toàn cầu hóa, giao thương du lịch dễ dàng giữa các quốc gia, nguy cơ bệnh xâm nhập vào mỗi quốc gia là hoàn toàn có thể. Do đó để phòng tránh dịch bệnh lây lan rộng trong cộng đồng, mỗi người dân cần nâng cao ý thức, tuân thủ các hướng dẫn của ngành y tế không chỉ với riêng bệnh đậu mùa khỉ mà còn với các bệnh truyền nhiễm khác.
Đưa ra khuyến cáo phòng ngừa bệnh đậu mùa khỉ trong tình hình hiện nay, bác sỹ Lương Chấn Quang nêu rõ: Bệnh đậu mùa khỉ lây truyền từ người qua người kể từ khi xuất hiện triệu chứng đầu tiên. Bệnh lây truyền chính qua tiếp xúc trực tiếp (bao gồm cả quan hệ tình dục), qua giọt bắn lớn. Để chủ động phòng, chống dịch bệnh đậu mùa khỉ, người dân cần thực hiện các biện pháp sau: Với bệnh nhân, người có triệu chứng sốt, phát ban cấp tính dạng mụn mủ quanh bộ phận sinh dục, lòng bàn tay, chân, thân mình, mặt, cần liên hệ ngay với cơ sở y tế để được theo dõi, tư vấn kịp thời; đồng thời, chủ động tự cách ly, tránh quan hệ tình dục.
Với người tiếp xúc với bệnh nhân, cố gắng tránh tiếp xúc gần với bệnh nhân đậu mùa khỉ, tránh tiếp xúc trực tiếp với những vết thương, dịch cơ thể, giọt bắn và các vật dụng, đồ dùng bị nhiễm mầm bệnh. Trong trường hợp nơi ở/nơi làm việc có người mắc hoặc nghi ngờ mắc bệnh, cần thông báo cho cơ quan y tế để được tư vấn và xử trí kịp thời, không tự ý điều trị.
Với người dân, kể cả bệnh nhân cần thường xuyên thực hiện các biện pháp phòng ngừa cá nhân, bao gồm: Che miệng và mũi khi ho hoặc hắt hơi, tốt nhất che bằng khăn vải hoặc khăn tay hoặc khăn giấy dùng một lần hoặc ống tay áo để làm giảm phát tán các dịch tiết đường hô hấp; rửa tay bằng xà phòng và nước sạch hoặc dung dịch sát khuẩn ngay sau khi ho, hắt hơi. Không khạc nhổ bừa bãi nơi công cộng. Thường xuyên rửa tay bằng xà phòng và nước sạch hoặc dung dịch sát khuẩn tay. Đảm bảo an toàn thực phẩm; thực hiện lối sống lành mạnh, tăng cường vận động thể lực, nâng cao sức khỏe.